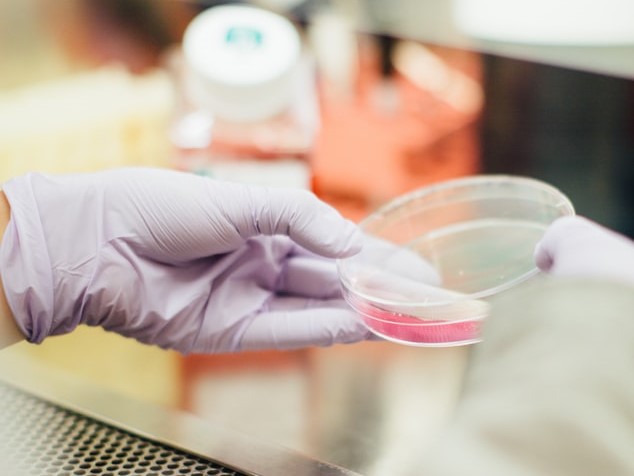

HIV/ AIDS
HIV Program
Aug 06, 202110 min read
Tanzania HIV/AIDS Background Information
It is currently estimated that around 1.4 million people are living with HIV in Tanzania. The HIV epidemic in the country is multifaceted. The HIV prevalence of 4.7% in the age group 15-49 years (THIS, 2016/17). Heterosexual sex remains the commonest (attributing up to 80%) route for HIV transmission in Tanzania Mainland. HIV prevalence in Tanzania is characterized by significant heterogeneity across age, gender, socioeconomic status, and geographic location, implying differentials in the risk of transmission. (Tanzania MoHCDGEC, 2021)
HIV prevalence is higher in sub-groups such as in People Who Inject Drugs (PWID) (16-51%), Men who have Sex with Men (MSM) (22-42%), and mobile populations and sex workers (14-35%). Women are disproportionally more affected, with an HIV prevalence of 6.3 % versus 3.9% among men. (THMIS 2011-12). The prevalence of HIV among young people aged 15-19 years was 1% (1.3% among girls, and 0.8% among boys). Furthermore, the percentage of women aged 20-24 infected with HIV is higher (4.4%) than that of men (1.7%) in the same age group. (Tanzania MoHCDGEC, 2021).
Attainment of global target i.e.,90-90-90 will lead to a reduction of new HIV infections by 90% ,hence providing an opportunity for ending the AIDS epidemic by 2030. The government has strengthened efforts to scale up HIV prevention, care, treatment, and support services including the recent adaption of the Treat All (test and treat) strategy. These efforts have resulted in a drop of HIV incidence rates from the peak of 1.34% in 1992 to as low as 0.07% among 15-24year-olds and 0.25% among adults (aged 15-64) in 2017. The country’s goal was to reduce the incidence in the general population to less than 0.16% by 2017.( Tanzania MOHCDEC, 2021).
The prevalence of HIV among young people aged 15-19 years was 1% (1.3% among girls, and 0.8% among boys). Furthermore, the percentage of women aged 20-24 infected with HIV is higher (4.4%) than that of men (1.7%) in the same age group
Roles and Responsibilities of Prime Health Initiative Tanzania (PHIT) in the fight against HIV/AIDS:
- To support all the global and local HIV initiatives to attain an AIDS-free Generation.
- To support the government of Tanzania and all stakeholders on the evidenced-based HIV preventive and curative interventions.
- To support and strengthen existing data capturing and reporting systems by embracing digital technology.
Our Priority Technical areas

Our Priority Technical areas:
- HIV cases diagnosis through the approved national HTS modalities in the Community and health facilities.
- Linkage of all the newly diagnosed HIV Clients to Care and Treatment (CTC).
- Retention into care and viral load suppression of the all the successful linked clients.
- Implementation of the scientific proven new HIV infections prevention interventions: comprehensive condoms promotion and use, Voluntary Male Medical Circumcision(VMMC), Prevention Mother to Child, Transmission (PMTCT), Pre and Post -Exposure Prophylaxis ( PrEP & PEP)
HIV Prevention:
PHIT believes that scaling up efforts to prevent HIV spread in Tanzania, particularly amongst young adults and adolescents, will go a long way to ensure a healthy future population, hence contributing to the attainment of SGD number 3
The PHIT is committed to supporting government of Tanzania efforts, through the Ministry of Health, Community Development Gender Elderly and Children, to ensure that WHO-recommended preventive strategies are implemented and scaled-up through the use of innovative approaches, to reach the goal of reducing HIV transmission rates in Tanzania.
Our key HIV prevention strategies include:
Our key HIV prevention strategies include:
- Promoting correct and consistent use of male and female condoms
- Harm reduction amongst people who inject and use drugs
- Testing and Counselling for HIV and Sexually Transmitted Infections (STIs), including HIV self-testing
- TB case identification, counselling, and treatment
- Voluntary Medical Male Circumcision (VMMC)
- Pre-exposure Prophylaxis (PrEP) for high-risk individuals
- Post-Exposure prophylaxis (PEP) for both occupational and non-occupational exposures, and
- Elimination of mother-to-child transmission of HIV (eMTCT)
Have a question? call us now
Need support? Drop us an email
Mon – Fri 08:00 – 17:30
We are open on

Prime Health Initiative - Tanzania
Mbezi Beach,Kinondoni, Tanzania
Information: +255 (786) 966 733
Land line: +255 (758) 966 733


